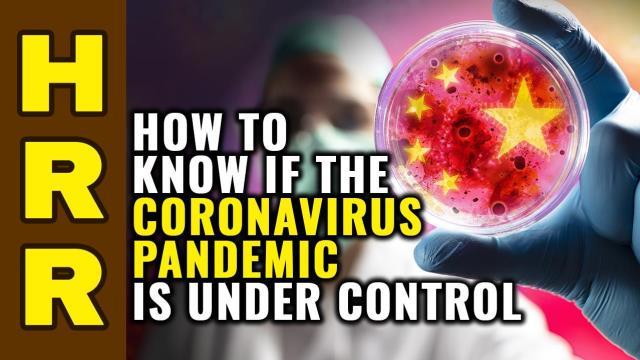

Trump is doing the RIGHT things to SLOW the spread
After a slow start, Trump is now doing a lot of the necessary things to slow the spread of the coronavirus.
Posted 3/24/2020 under Survival and Prepping • Share
Related Episodes
Comments
Advertisement